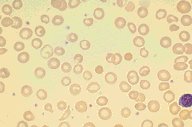

Description
This is a high dry view of a Wright's stained peripheral blood
smear from a patient with iron deficiency anemia. A normal
lymphocyte for comparison purposes is seen in the corner of the
photograph. Significant hypochromia and microcytosis is seen, as
well as moderate variation in size and shape of the red cells.
|
|
Click on this image
to enlarge it, then
on Back buttom
in the Netscape Menu
to shrink it back down



|